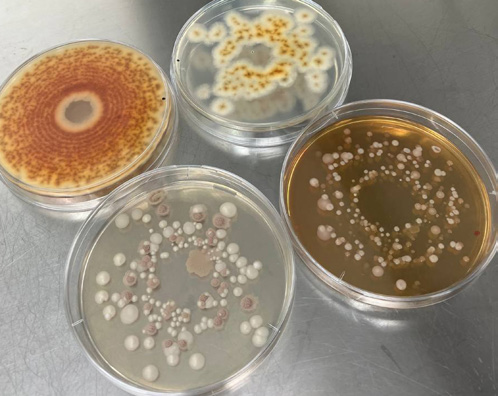
piastre petri

Studiato il comportamento della flora microbica durante l’insilamento.
Pubblicato su Informatore Zootecnico, n 8/2024
L’innovativo servizio di analisi microbiologica di Pioneer Hi-Bred Italia, presentato nel contesto dell’ultima Fiera internazionale del bovino da latte a Cremona, è stato definito come un’innovazione nel mondo dell’assistenza tecnica sulla qualità dei foraggi. Nel primo anno di disponibilità del servizio, più di 1.000 campioni, tra foraggi insilati, unifeed e foraggi verdi sono già stati analizzati presso il Corteva Agrolab di Cremona, l’avanzato laboratorio dedicato ai servizi analitici offerti dalla società agli agricoltori.
Oltre a rappresentare un servizio tecnico dall’indiscutibile valore aggiunto in centinaia di aziende, uno degli obiettivi principali del progetto di Pioneer è stato quello di verificare e misurare sul campo, attraverso test e analisi, alcuni aspetti della microbiologia dell’insilamento riportati in letteratura ma spesso poco considerati nella pratica. Tra gli elementi da sempre dibattuti quando si parla di microbiologia vi è senz’altro quello relativo a come la flora microbica presente sulla pianta sia coinvolta nel processo di conservazione, considerando la sua ampia variabilità botanica e stagionale (Pahlow, 2003).
Questo fenomeno è dovuto alla differenza del metabolismo dei diversi microrganismi che si trovano sulla superficie fogliare del foraggio al momento della raccolta e che si sviluppano con cinetiche di accrescimento diverse a seconda della specie botanica della coltura e soprattutto dell’ambiente colturale.
La prima fase della sperimentazione ha avuto come obiettivo esaminare in un ambiente di laboratorio, con condizioni di crescita monitorate, le curve di accrescimento di lieviti e batteri lattici isolati da campioni raccolti sul campo e fatti crescere in terreni di coltura specifici. È stato quindi misurato il tempo di crescita e lo sviluppo dei microrganismi in condizioni standardizzate e a diverse temperature, osservando come nel range che va da 10 a 30°C la capacità di replicazione dei lieviti risulti più alta di quella dei batteri lattici (grafico 1).

Grafico 1 - Velocità di replicazione oraria di lieviti e batteri lattici in condizioni sperimentali controllate. Clicca per ingrandire.
Il passaggio successivo è stato quello di spostare l’applicazione di queste evidenze dal laboratorio al campo, concentrandosi sul triticale come esempio di cereale autunno-vernino di interesse zootecnico. Durante la campagna 2023 in sette differenti località della Pianura Padana è stato monitorato l’andamento della popolazione di muffe, lieviti e batteri lattici espresso in unità formati colonia (Cfu/gr Tq) durante le ultime sette settimane di accrescimento della coltura prima della trinciatura.
I risultati
I risultati ottenuti hanno nuovamente confermato quanto la bibliografia e il test di laboratorio suggerivano: le popolazioni di batteri lattici, soffrendo molto di più le basse temperature, risultano essere meno presenti in termini di popolazione sulla pianta rispetto a muffe e lieviti (grafici 2 e 3).

Grafico 2 - Conta delle Unità formanti colonia per grammo di pianta, prelevato nelle ultime 7 settimane prima della trinciatura. Esempio riferito a una prova condotta a Mantova. Clicca per ingrandire.
Avendo una maggiore capacità di riprodursi in situazioni critiche, infatti, muffe e lieviti si trovano in una condizione iniziale di vantaggio. I batteri lattici crescono più lentamente tendendo poi ad accelerare il proprio sviluppo con l’avanzare della stagione.

Grafico 3 - Conta delle Unità formanti colonia per grammo di pianta, prelevato nelle ultime 7 settimane prima della trinciatura. Esempio riferito a una prova condotta a Piacenza. Clicca per ingrandire.
Quello che però è stato possibile constatare su ogni campo monitorato è come, a ogni evento di stress termico legato ad abbassamenti di temperatura, la dimensione della popolazione dei batteri lattici è risultata sempre compromessa, riducendo quindi le Cfu presenti sulla pianta. Le muffe e i lieviti invece, non hanno mai risentito negativamente degli stress ambientali, incrementando la dimensione della popolazione. Specialmente i lieviti sono risultati molto più favoriti rispetto al resto della flora microbica.
Il monitoraggio sui cereali autunno-vernini ha potuto quindi confermare un aspetto chiaro, che spiega anche la minore efficienza fermentativa dei cereali e delle leguminose raccolte nel periodo primaverile. Se infatti la quota di batteri lattici sulla pianta è normalmente già minore in termini assoluti rispetto agli altri microrganismi, l’andamento termico della prima metà dell’anno tende a sfavorirli ulteriormente. Al contrario le popolazioni di lieviti e muffe risultano avvantaggiate, rendendo quindi più complessa la conservazione degli insilati.
Senza considerare quanto l’efficienza fermentativa dei batteri lattici naturalmente presenti sia sempre soggetta alla variabilità genetica dei ceppi che sopravvivono alle condizioni di stress ambientale e termico. L’utilizzo di additivi microbiologici durante la raccolta permette di andare a inoculare il trinciato con la giusta quota di batteri lattici necessari per avviare le fermentazioni in maniera ottimale. Inoltre, permette alle aziende di scegliere i migliori ceppi batterici in grado di offrire un vero e proprio effetto “additivo”, come una superiore stabilità aerobica e una migliore efficienza nutrizionale degli insilati.
Pioneer, oltre a offrire da sempre le più innovative soluzioni per la conservazione dei foraggi con additivi microbiologici ad attività specifica, affianca le aziende con un servizio analitico di alto livello grazie al Corteva Agrolab che, con i suoi servizi analitici pensati a misura di azienda, supporta coltivatori e allevatori dalla semina alla raccolta per produrre foraggi insilati della migliore qualità.